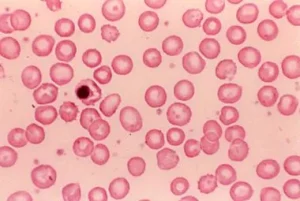
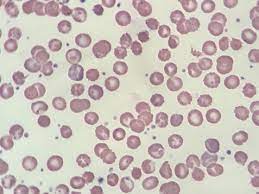

Fosfataz eksikliği, vücudun belirli bir enzim olan fosfatazın üretiminde veya fonksiyonunda bir bozulma yaşaması sonucu ortaya çıkan nadir bir hastalıktır. Fosfatazlar, hücrelerin normal fonksiyonlarını sürdürebilmesi için gerekli olan önemli enzimlerdir. Bu enzimler, fosfat gruplarının kimyasal bileşiklerden serbest bırakılmasını sağlar ve hücresel süreçlerin düzenlenmesinde kritik bir rol oynar. Fosfataz eksikliği, vücudun kemik, dişler ve kaslar gibi yapıların normal gelişimi ve fonksiyonlarını olumsuz etkileyebilir.
Fosfataz Enziminin Rolü ve Önemi
Fosfataz enzimleri, fosforilasyon ve defosforilasyon işlemlerinde yer alan enzimlerdir ve hücresel süreçlerde büyük öneme sahiptir. Fosfatazlar, vücutta kimyasal bağların koparılmasına yardımcı olan önemli biyolojik katalizörlerdir. Bu enzimler, özellikle hücresel sinyal iletiminde, enerji üretiminde, proteinlerin aktif hale gelmesinde ve gen ekspresyonunun düzenlenmesinde rol oynar.
Fosfataz eksikliği, bu enzimlerin yeterince üretilememesi veya düzgün çalışmaması sonucunda hücresel işlevlerin aksamasına yol açar. Fosfatazın işlevselliği, kemik dokusunun sağlıklı gelişimi, kasların düzgün çalışması, ve bağışıklık sistemi fonksiyonları gibi kritik alanları etkileyebilir.
Fosfataz Eksikliğinin Nedenleri
Fosfataz eksikliği genetik bir hastalık olarak sınıflandırılır ve genellikle doğuştan gelir. Yani, bu hastalık ebeveynlerden birinden veya her ikisinden miras alınan genetik bir mutasyon sonucu ortaya çıkar. Genetik faktörlerin dışında, bazı nadir hastalıklar veya tıbbi durumlar da fosfataz eksikliğine neden olabilir. Örneğin, bazı metabolik hastalıklar, endokrin bozukluklar veya bağışıklık sistemi ile ilgili sorunlar fosfataz eksikliğine yol açabilir.
Fosfataz eksikliği, özellikle kemik ve diş gelişimi üzerinde önemli etkiler yaratabilir. Fosfataz enzimi, kemiklerin mineralizasyonunda kritik bir rol oynar. Bu eksiklik nedeniyle kemikler ve dişler, normalden daha zayıf ve kırılgan olabilir.
Fosfataz Eksikliğinin Türleri
Fosfataz eksikliği, farklı türlerde ve derecelerde görülebilir. Bunlar, eksik fosfataz türüne ve vücudun hangi sistemlerinin etkilendiğine bağlı olarak çeşitlenir. Bu hastalık genellikle iki ana kategoriye ayrılır:
Alkalin Fosfataz Eksikliği
Alkalin fosfataz, genellikle kemiklerde, karaciğerde ve bağırsaklarda bulunan bir enzim türüdür. Alkalin fosfataz eksikliği, genetik bir hastalık olarak çoğunlukla kemik gelişimi üzerinde etkili olur ve osteomalaziye (kemiklerin yumuşaması) yol açabilir. Alkalin fosfataz eksikliği genellikle bebeklik döneminde veya erken çocuklukta teşhis edilir.Asidik Fosfataz Eksikliği
Asidik fosfataz, genellikle lysosomalarda bulunan bir enzimdir ve hücrelerin atık maddeleri parçalamak için bu enzimi kullanır. Asidik fosfataz eksikliği, lysosomal depolama hastalıklarıyla ilişkilidir ve bu hastalıklar genellikle nörolojik problemlere yol açar. Bu tip eksiklik, genellikle vücuttaki diğer sistemleri, özellikle sinir sistemi üzerinde derin etkiler yapar.
Fosfataz Eksikliğinin Belirtileri
Fosfataz eksikliğinin belirtileri, eksik olan fosfataz türüne ve hangi organ sistemlerinin etkilendiğine bağlı olarak değişir. Bazı yaygın belirtiler şunlar olabilir:
- Kemik ve Diş Problemleri: Fosfataz eksikliği, kemiklerin mineralizasyonunu engelleyebilir ve bu da kemiklerde zayıflığa, kırılganlığa veya deforme olmasına neden olabilir. Dişlerde de benzer şekilde zayıflık ve çürükler görülebilir.
- Kas Gücü Kaybı: Kaslar, fosfataz enzimi eksikliğinden etkilenebilir, bu da kas güçsüzlüğüne, ağrısına ve fonksiyon kaybına yol açabilir.
- Büyüme Gecikmesi: Çocuklar ve bebekler arasında büyüme ve gelişim geriliği görülebilir.
- Nörolojik Sorunlar: Asidik fosfataz eksikliği, nörolojik problemleri tetikleyebilir. Sinir hücrelerinin düzgün çalışmaması, koordinasyon eksiklikleri, zihin gelişimindeki gerilikler gibi belirtilerle kendini gösterebilir.
Fosfataz Eksikliği Tanısı
Fosfataz eksikliğinin tanısı genellikle kan testleri ve genetik testler ile konur. Alkalin fosfataz seviyesi, özellikle kemik, karaciğer ve bağırsak sağlığı açısından önemli bir göstergedir. Düşük alkalin fosfataz seviyeleri, fosfataz eksikliği ve buna bağlı hastalıkları işaret edebilir. Ayrıca, asidik fosfataz testleri de lysosomal hastalıkların tanısında kullanılır.
Genetik testler, özellikle nadir fosfataz eksiklikleri için tanı koymada yardımcı olabilir. Bu testler, eksik olan veya bozulmuş genetik mutasyonları tespit edebilir ve hastalığın kesin teşhisini sağlamak için önemlidir.
Fosfataz Eksikliğinin Tedavisi
Fosfataz eksikliği tedavisi, hastalığın türüne, şiddetine ve belirtilere bağlı olarak değişiklik gösterir. Genetik bir hastalık olan fosfataz eksikliği için spesifik bir tedavi bulunmamaktadır. Ancak, tedavi yöntemleri semptomları yönetmeye ve yaşam kalitesini iyileştirmeye yöneliktir.
- Alkalin Fosfataz Eksikliği Tedavisi: Alkalin fosfataz eksikliği tedavisinde, kemik sağlığını iyileştirmek için kalsiyum ve D vitamini takviyeleri verilebilir. Ayrıca, fiziksel terapi, kas güçsüzlüğünü iyileştirmeye yardımcı olabilir.
- Asidik Fosfataz Eksikliği Tedavisi: Asidik fosfataz eksikliği tedavisinde, tedavi daha çok semptomları hafifletmeye yönelik olabilir. Örneğin, nörolojik belirtiler için nöroloji uzmanları tarafından tedavi uygulanabilir.
Fosfataz eksikliği, uzun vadede tedavi edilmezse ciddi sağlık sorunlarına yol açabilir, bu yüzden hastalığın erken dönemde teşhis edilmesi ve uygun tedavi yöntemlerinin uygulanması çok önemlidir.
Fosfataz Eksikliğinin Önlenmesi ve Yönetimi
Fosfataz eksikliği genetik bir durum olduğu için doğrudan bir önlenmesi yoktur. Ancak, genetik danışmanlık, ailelerin bu hastalığın varlığı hakkında bilgi sahibi olmalarını ve bu hastalığa sahip çocukların sağlıklı bir yaşam sürmeleri için gerekli tedbirleri almalarını sağlar. Ayrıca, fosfataz eksikliği olan bireylerin düzenli doktor kontrollerine gitmesi ve semptomların yönetilmesi önemlidir.